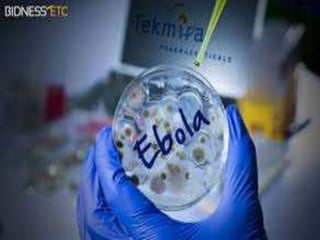

The Ebola virus has caused several outbreaks in Africa since 1976. It is transmitted through direct contact with bodily fluids and can cause hemorrhagic fever with severe symptoms and high fatality rates. While there is no approved vaccine or treatment, outbreaks are managed through isolation protocols, contact tracing, and supportive care to control symptoms. Diagnosis involves blood tests to detect antibodies or the virus's genetic material. The threat of Ebola epidemics remains due to the virus's history of recurring outbreaks in Central Africa.

![“The BioFire Defense
FilmArray NGDS BT-E Assay
• It will take the Ebola cells, break
them open, expose the
[ribonucleic acid] in the Ebola
and match those with a target
that is identified.](https://image.slidesharecdn.com/ebolapresentation-150402011908-conversion-gate01/85/Ebola-presentation-32-320.jpg)





















